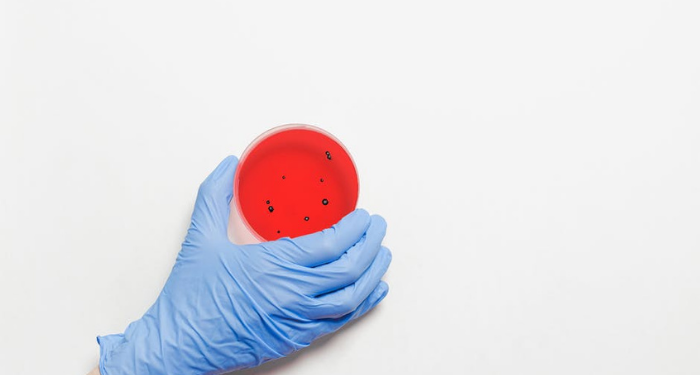
Kisah Umar bin Khattab Menghindari Tempat yang Penuh Wabah Penyakit

ChanelMuslim.com – Kisah Umar bin Khattab menghindari tempat yang penuh dengan wabah penyakit bisa kita ambil pelajaran. Dari keputusan Umar ini, kita bisa melihat kebijaksanaan Umar. Tentunya, hal ini bisa dicontoh pada zaman sekarang karena saat ini pun wabah penyakit sedang menyebar di seluruh dunia.
Baca Juga: Menjadi Abdullah bin Umar, Anak dari Umar bin Khattab ra.
Kisah Umar bin Khattab Menghindari Tempat yang Penuh Wabah Penyakit
Dikisahkan bahwa sahabat Nabi, Umar bin Khattab Radhiyallaahu Anhu bersama para sahabat Nabi yang lain pernah akan masuk ke negeri Syam.
Saat itu, negeri tersebut sedang terkena wabah penyakit tha’un. Umar kemudian bermusyawarah dengan para sahabat yang lain.
Ada yang menganjurkan terus masuk, ada yang menganjurkan kembali ke Madinah. Umar kemudian memutuskan untuk kembali ke Madinah.
Sebagian orang yang ada bertanya, “Apakah engkau akan lari dari Takdir Allah, wahai Amirul Mukminin?”
Umar menjawab dengan jawaban yang sangat baik dan menunjukkan pemahaman yang benar tentang takdir.
نَعَمْ نَفِرُّ مِنْ قَدَرِ اللَّهِ إِلَى قَدَرِ اللَّهِ
Ya, kita lari dari Takdir Allah menuju Takdir Allah. (H.R Muslim no 4114).
Kemudian, Umar berkata :
أَرَأَيْتَ لَوْ كَانَتْ لَكَ إِبِلٌ فَهَبَطَتْ وَادِيًا لَهُ عُدْوَتَانِ إِحْدَاهُمَا خَصْبَةٌ وَالْأُخْرَى جَدْبَةٌ أَلَيْسَ إِنْ رَعَيْتَ الْخَصْبَةَ رَعَيْتَهَا بِقَدَرِ اللَّهِ وَإِنْ رَعَيْتَ الْجَدْبَةَ رَعَيْتَهَا بِقَدَرِ اللَّهِ
Bagaimana pendapatmu jika engkau memiliki unta yang turun ke lembah memiliki 2 sisi. Yang satu subur dan yang satu tandus.
Bukankah jika engkau menggembalakan di tempat subur, engkau gembalakan untamu berdasarkan takdir Allah. Dan jika engkau gembalakan di tempat tandus, engkau gembalakan dengan takdir Allah? (H.R Muslim no 4144).
Dalam suatu hadits dinyatakan :
سُئِلَ رَسُولُ اللَّهِ صَلَّى اللَّهُ عَلَيْهِ وَسَلَّمَ أَرَأَيْتَ أَدْوِيَةً نَتَدَاوَى بِهَا وَرُقًى نَسْتَرْقِي بِهَا وَتُقًى نَتَّقِيهَا هَلْ تَرُدُّ مِنْ قَدَرِ اللَّهِ شَيْئًا قَالَ هِيَ مِنْ قَدَرِ اللَّهِ
Rasulullah Shollallahu Alaihi Wasallam ditanya: “Bagaimana pendapat Anda tentang pengobatan (terhadap) penyakit yang kita upayakan, atau ruqyah yang kita lakukan, atau tameng yang kita gunakan untuk melindungi diri.
Apakah hal itu bisa menolak takdir Allah? Rasul Bersabda : Itu (Semua) adalah termasuk Takdir Allah.” (H.R atTirmidzi, Ibnu Majah, dishahihkan oleh Ibnu Hibban dan al-Iraqy dalam Thorhut tastriib (4/228), dihasankan Syaikh al-Albany dalam takhrij musykilatil faqr no 11).
Sahabat Muslim, semoga kita semua bisa bersikap lebih bijak dalam menghadapi pandemi di negeri tercinta ini. Mari selalu menjaga diri kita dari wabah ini. [Cms]
Dikutip dari Buku “Akidah Imam Al-Muzani (Murid Imam Asy-Syafii)”
Ustaz Abu Utsman Kharisman Hafidzahullah.
http://telegram.me/alistiqomah